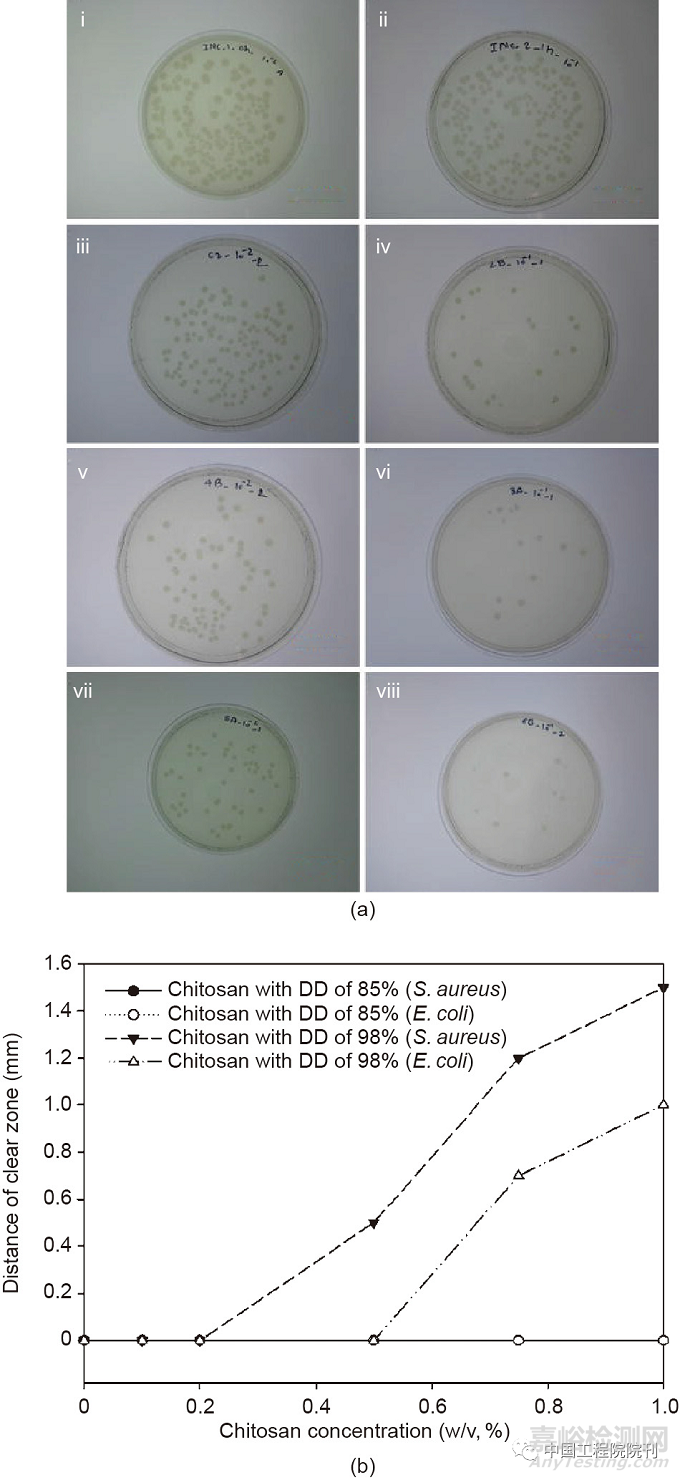
紡織品等離子體輔助抗菌整理技術(shù)

您當(dāng)前的位置:檢測資訊 > 科研開發(fā)
嘉峪檢測網(wǎng) 2022-11-21 22:44
編者按
微生物會對紡織品產(chǎn)生有害影響,并常常對紡織品的穿著者產(chǎn)生影響??咕砑夹g(shù)可以保護(hù)紡織品不受微生物的破壞,提高耐久性,同時(shí)保護(hù)穿著者不受微生物感染。紡織品的傳統(tǒng)抗菌整理工藝采用的是濕式處理方法,即采用填充—干燥—固化或排氣技術(shù),但紡織品濕處理行業(yè)是世界范圍內(nèi)引起環(huán)境污染的主要原因之一。因此,尋求更快的、經(jīng)濟(jì)的和環(huán)保的技術(shù)極為重要。等離子體輔助整理技術(shù)具有快速、經(jīng)濟(jì)和環(huán)保等優(yōu)點(diǎn),是一種很有前景的紡織品整理技術(shù)。
中國工程院院刊《Engineering》2022年第5期刊發(fā)澳大利亞迪肯大學(xué)Maryam Naebe研究員科研團(tuán)隊(duì)的《紡織品等離子體輔助抗菌整理技術(shù)概述》一文,通過對近期研究的批判性分析,回顧了等離子體在紡織品抗菌整理技術(shù)中的應(yīng)用原理,并強(qiáng)調(diào)了用于實(shí)際應(yīng)用的等離子體技術(shù)的類型和機(jī)制。文章指出,利用等離子體輔助進(jìn)行抗菌整理的研究已經(jīng)采用了多種方法,包括整理劑在紡織品基材上的接枝聚合,改變紡織品的功能(如潤濕性)以增強(qiáng)整理劑的負(fù)載,等離子體濺射,以及在紡織品上合成納米顆粒以進(jìn)行抗菌保護(hù)。結(jié)果表明,所有的研究技術(shù)都取得了良好的效果,適合在抗菌整理中使用等離子體。等離子體在紡織品抗菌整理中的應(yīng)用可以開創(chuàng)紡織品制造的新時(shí)代,實(shí)現(xiàn)可持續(xù)的環(huán)境和更健康的生活。
一、引言
微生物是只在微觀范圍內(nèi)被感知的生物體。它們在地球上幾乎隨處可見,或是以單細(xì)胞形式,或是以細(xì)胞群的形式出現(xiàn)。最常見的微生物是真菌、細(xì)菌和病毒,其中前兩種是在紡織材料上暴發(fā)疫情的主要原因。但紡織品也可以通過加工來實(shí)現(xiàn)抗病毒的特性,從而有助于防止病毒的傳播。盡管對紡織品抗病毒性能的研究仍處于新興階段,但紡織品的抗真菌和抗菌性能已被廣泛研究。
抗菌整理技術(shù)可以保護(hù)紡織品不受微生物的破壞,提高耐久性,同時(shí)保護(hù)穿著者不受微生物感染。未加工的紡織材料上的微生物干擾與用抗菌劑加工的紡織品的對比示意圖如圖1所示。除了真菌和細(xì)菌之外,在目前新冠疫情中,如果為紡織品提供抗病毒處理,那么使用紡織品來阻礙病毒傳播的意義和機(jī)會就成為人們關(guān)注的焦點(diǎn)。因此,紡織品的抗菌整理技術(shù)正在成為一個(gè)非常重要的問題,并得到了極大的關(guān)注。

圖1. 微生物對未完成的紡織品的攻擊(a)和成品紡織品對微生物的抗菌活性(b)的示意圖。
到目前為止,已經(jīng)有幾種方法被用于將抗菌劑應(yīng)用于紡織品。一種方便的抗菌整理技術(shù)是在涂料溶液中使用整理劑,在紡紗過程中通過噴絲板和凝固浴形成紡織纖維。這種方法能產(chǎn)生非常耐用的整理,因?yàn)檎韯┏蔀榱死w維本身的一個(gè)組成部分。但這種方法只能應(yīng)用于再生纖維或合成纖維,而不是天然纖維。墊干固化技術(shù)(pad-dry-cure technique)是一種廣泛使用的方法,用于對由天然或合成纖維制成的紡織品進(jìn)行整理。然而盡管這是一種具有工業(yè)規(guī)模的實(shí)用方法,但它有一些主要的缺點(diǎn)。例如,填充物會產(chǎn)生70%~100%的濕吸附,需要通過能源密集型的干燥過程來蒸發(fā)水分。此外,在蒸發(fā)過程中,整理劑會在織物表面發(fā)生遷移,這往往會導(dǎo)致整理不均勻。另一種常用的整理技術(shù)是排氣或浸漬,這也需要用水作為介質(zhì)并進(jìn)一步干燥。一些先進(jìn)的抗菌整理方法也已被報(bào)道,包括溶膠-凝膠技術(shù)和逐層沉積。溶膠-凝膠技術(shù)是一種將織物浸漬在溶膠(一種逐漸變?yōu)槟z形式的膠體溶液)中,然后通過后續(xù)的填充和干燥-洗滌系統(tǒng)的方法。逐層沉積技術(shù)是將織物在一個(gè)步驟中浸入陽離子聚合物溶液,在另一個(gè)步驟中浸入陰離子聚合物溶液,依次沉積聚合物層。在這種技術(shù)中,在兩次浸漬操作之間需要對織物進(jìn)行漂洗和干燥。盡管這些方法相對來說比傳統(tǒng)的濕法整理更有效,但使用水和能源進(jìn)行干燥仍然是一個(gè)令人擔(dān)憂的問題。文獻(xiàn)中已經(jīng)報(bào)道了一些相對干燥的抗菌整理技術(shù)。例如,已經(jīng)報(bào)道了紫外線固化殼聚糖在棉花和絲綢上的沉積以賦予其抗菌特性,其中織物被浸泡在含有光敏引發(fā)劑的殼聚糖溶液中,然后在固化過程之前進(jìn)行干燥。在另一項(xiàng)研究中,報(bào)道了在棉花上原位生成和沉積氧化鋅納米顆粒(ZnONP)的情況,將織物浸入乙酸鋅水/乙醇溶液中,在超聲燒瓶中照射30 min(20 kHz, 750 W),然后清洗和干燥。盡管達(dá)到的抗菌性能令人鼓舞,但考慮到水和隨后干燥的必要性,這些方法并不是完全干燥或節(jié)能的。
在傳統(tǒng)工藝中需要大量的水(隨后產(chǎn)生廢水)和隨后的能源密集型的干燥過程,這意味著工業(yè)對高效和環(huán)境友好的替代解決方案具有極大的興趣。在這種情況下,在紡織品整理中使用等離子體是一種獨(dú)特的方法,可以大大減少水和能源的使用,因?yàn)榈入x子體處理不需要水或干燥,從而節(jié)省大量的水和能量。圖2說明了與傳統(tǒng)的濕法技術(shù)(如墊干固化法)相比,在抗菌整理中使用等離子體的優(yōu)勢。紡織品的等離子體輔助抗菌整理是通過聚合物沉積或接枝聚合實(shí)現(xiàn)的。聚合物沉積涉及通過將抗菌整理聚合物以薄膜的形式散布在紡織基材上而將其納入其中,而接枝聚合則是將抗菌整理劑與紡織品表面結(jié)合起來。此外,即使將等離子體作為整理前的預(yù)處理過程,紡織品的基本功能特性(如吸收性)也可以得到極大的改善,而且可以用更少的水和時(shí)間達(dá)到類似的整理效果。

圖2. 墊干固化法(a)和紡織品抗菌整理(b)的典型等離子體應(yīng)用的示意圖。
考慮到紡織品抗菌整理的重要性以及等離子體參與時(shí)整理效果的根本改善,等離子體輔助的紡織品抗菌整理是一個(gè)最令人感興趣的話題。但現(xiàn)有的相關(guān)綜述是基于在紡織品上使用的抗菌整理劑或使用等離子體時(shí)可達(dá)到的功能和效率。到目前為止,還沒有詳細(xì)的綜述集中于等離子體輔助抗菌整理對紡織品的重要性。因此,本文的主要目的是關(guān)注和討論使用等離子體對紡織品進(jìn)行抗菌整理,并研究其原理和未來的機(jī)遇。為了實(shí)現(xiàn)這一目標(biāo),我們討論了微生物侵害的機(jī)制、抗菌劑的類型、抗菌測試的方法和等離子體及其機(jī)制,然后對各種紡織材料的等離子體輔助抗菌整理進(jìn)行了嚴(yán)格的評估。
二、微生物對紡織品的侵害機(jī)制
微生物(主要是真菌和細(xì)菌)可以在紡織材料的使用和儲存期間在其上繁殖。潮濕的環(huán)境和紡織品吸收水分的傾向會促進(jìn)微生物的生長。由于天然纖維的吸濕能力相對較強(qiáng),因此天然纖維的紡織品比合成纖維更容易受到微生物的侵害。微生物會對紡織品造成視覺和功能上的改變,也會對其造成不衛(wèi)生的問題,對穿著者造成傷害。如上所述,在微生物中,真菌和細(xì)菌是對紡織材料最有害的。其中,真菌大多是造成變色、污漬和纖維損壞的原因。雖然細(xì)菌不像真菌那樣具有破壞性,但它們會產(chǎn)生難聞的氣味,并會導(dǎo)致紡織品表面出現(xiàn)黏稠的紋理。
微生物對紡織材料的影響通常與兩個(gè)主要現(xiàn)象有關(guān):同化和降解。同化作用是指微生物(即真菌和細(xì)菌)將紡織品作為其營養(yǎng)來源的階段。植物性纖維(如棉花)中的碳水化合物和動物性纖維(如羊毛)中的蛋白質(zhì)可作為微生物的營養(yǎng)源。例如,棉花更容易受到真菌的侵害而不是細(xì)菌的侵害,而羊毛則更容易受到細(xì)菌的侵害而不是真菌的侵害。
微生物可以侵害整個(gè)材料,也可以只侵害單一的成分,如存在于表面的污垢或加入紡織品中的任何適合它們生長的添加劑。微生物為收集食物而產(chǎn)生胞外酶,導(dǎo)致紡織品特性的物理變化,如失去強(qiáng)度和彈性。植物纖維(如棉花、黃麻、大麻和亞麻)更容易受到纖維素分解真菌產(chǎn)生的纖維素酶的侵害。此外,許多真菌可以產(chǎn)生色素,因此能夠?qū)е录徔椘纷兩S捎谄浣Y(jié)構(gòu)與纖維素相似,再生纖維素纖維(如黏膠、乙酸纖維和三乙酸纖維)也容易受到微生物侵害。蛋白質(zhì)纖維,如羊毛和絲綢,對真菌的抵抗力比植物纖維高。但在不利的條件下,由于真菌和細(xì)菌產(chǎn)生的蛋白分解(蛋白質(zhì)降解)酶的作用,會損害蛋白質(zhì)纖維。合成纖維,如聚酯(PET)、尼龍和丙烯酸,對微生物有相當(dāng)?shù)牡挚沽?。但其鏈條中存在的添加劑,如抗靜電劑、潤滑劑和增稠劑,以及污垢、土壤和灰塵的存在,會促使微生物的生長。此外,穿著者的身體廢物,即汗液和皮脂,會促進(jìn)紡織品中微生物的生長。
在紡織品表面看到的小斑點(diǎn)或氣泡往往發(fā)生在微生物生長的初始階段。然后,通過微生物在纖維腔內(nèi)的滲透和鍵的斷裂,降解階段成為主導(dǎo),這對物理性能(如質(zhì)量損失)、力學(xué)性能(斷裂強(qiáng)度的降低)和化學(xué)性能(如纖維素或蛋白質(zhì)的降解)產(chǎn)生不利影響。
三、抗菌整理劑的類型
多年來,人們提出了各種抗菌整理劑來防止微生物對紡織品的侵害。這些產(chǎn)品包括:金屬化合物和納米顆粒、有機(jī)化合物[季銨鹽化合物(QAC)、聚雙胍、N-鹵胺和三氯生(2,4,4-三氯-2-羥基二苯醚)]、天然聚合物和染料,如殼聚糖和植物提取物。表1列出了紡織品應(yīng)用中最常見的幾種抗菌劑及其優(yōu)點(diǎn)和缺點(diǎn)。
表1 紡織品中常用的抗菌劑類型及其優(yōu)點(diǎn)和缺點(diǎn)

重金屬,如銀、銅和鋅,以及金屬氧化物,如二氧化鈦和金屬鹽,已被普遍用于紡織材料的抗菌整理。這些金屬或金屬化合物顯示出有效的抗菌性能,因?yàn)樗鼈兡軌蜃柚刮⑸锏腄NA復(fù)制,導(dǎo)致細(xì)胞質(zhì)膜的不規(guī)則運(yùn)行,排出細(xì)胞內(nèi)的成分,并破壞蛋白質(zhì)的連接。這些化合物在非常低的濃度下對微生物是有毒的,可以使微生物失去活性或殺死它們。在這些無機(jī)化合物中,銀因其對人體的低毒性而最常被用于紡織品。市場上有許多可以直接應(yīng)用于紡織品的銀基商業(yè)抗菌整理產(chǎn)品,如AlphaSan(Milliken,美國)、MicroFresh(O’Mara,美國)和Silpure(Thomson Research Associates,加拿大)。
最近,通過使用金屬納米顆粒,金屬化合物在紡織品中的抗菌活性得到了改善。這是因?yàn)榧{米顆粒具有獨(dú)特的物理化學(xué)特性,并具有較高的表面積與體積比,這在與微生物接觸時(shí)表現(xiàn)得很有利。盡管銀納米顆粒(AgNP)、二氧化鈦納米顆粒(TiO2NP)、氧化鋅納米顆粒(ZnONP)和銅納米顆粒(CuNP)都是最經(jīng)常報(bào)道的用于紡織品的抗菌整理劑,但AgNP仍然是最佳材料。盡管在使用可穿透人體皮膚的小顆粒(?10 nm)時(shí),存在與金屬納米顆粒相關(guān)的毒性問題,但由于AgNP的低毒性和廣泛的抗菌活性,其應(yīng)用已被廣泛研究。許多研究報(bào)道,當(dāng)AgNP被用于關(guān)鍵的紡織纖維,如棉花、羊毛、絲綢、聚酯和聚酰胺時(shí),微生物會減少約99.9%。相對而言,其他用于紡織品抗菌整理的納米顆粒,除了一些例外,大多是在棉花上應(yīng)用的報(bào)道。
除了上述的無機(jī)來源,各種有機(jī)化合物也被廣泛用于紡織品的抗菌整理。例如,QAC被廣泛用于此目的。QAC的抗菌性能取決于其烷基鏈的長度,通常約12~18個(gè)碳原子顯示出良好的抗菌活性。QAC中的陽離子有助于其附著在帶負(fù)電荷的紡織纖維表面,并與帶電負(fù)性的細(xì)胞膜形成QAC/微生物復(fù)合物。QAC/微生物復(fù)合物的形成破壞了微生物的蛋白質(zhì)活性和功能。它還通過干擾微生物的DNA來降低其繁殖能力。
除了QAC之外,聚雙胍、N-鹵胺和三氯生是另外三組用于紡織品的合成有機(jī)抗菌劑。聚雙胍由陽離子雙胍組成,被長的碳?xì)滏湻指?。聚雙胍的聚合物鏈較長,可提供更多的陽離子位點(diǎn),從而使抗菌活性更高。在所使用的聚雙胍中,聚六亞甲基雙胍(最低抑制濃度為0.5~10 ppm)是紡織品中最常用的抗菌整理劑。N-鹵胺是具有一個(gè)或兩個(gè)鹵素(X)與氮(N)共價(jià)鍵的雜環(huán)化合物。在有水的情況下,鹵素離子被氫離子取代(N?H),然后與微生物結(jié)合,停止其代謝和酶促的過程。由于應(yīng)用N-鹵胺會在織物表面留下大量的游離鹵素(通常是氯),因此需要進(jìn)一步的還原過程以避免織物變色和產(chǎn)生難聞的氣味。三氯生是一種有機(jī)合成聚合物,是一種適合抑制多種微生物生長的抗菌劑。由于三氯生的分子尺寸較小,它被用于紡織材料,如分散染料。在紡織品使用過程中,三氯生的緩慢釋放導(dǎo)致了抗菌活性。
盡管上述的合成抗菌劑已被證明在紡織品上是有效和持久的,但它們的缺點(diǎn)之一是對人類健康和周圍環(huán)境的有害影響。在這方面,可以考慮一些天然聚合物和染料,因?yàn)樗鼈兙哂协h(huán)境友好的性質(zhì)和確定的抗菌活性。在天然抗菌劑中,殼聚糖可能是使用最廣泛的具有抑菌活性的聚合物。殼聚糖是一種去乙?;募讱に?,是僅次于纖維素的第二大多糖。由于殼聚糖中的胺基提供了正電荷,它們與微生物中的負(fù)電荷相互作用,改變了微生物的細(xì)胞表面和通透性,同時(shí)在其分子中產(chǎn)生泄漏。這可以通過滲透到微生物的細(xì)胞核中抑制信使RNA(mRNA)蛋白的合成。此外,殼聚糖可以與金屬離子形成螯合物,這對微生物的生長至關(guān)重要。殼聚糖在棉花、絲綢、聚酯、黏膠等方面經(jīng)常被研究,并作為抗菌整理劑(甚至作為納米顆粒),使用交聯(lián)劑可以進(jìn)一步提高它在紡織品上的耐久性。但由于它只有在較高的濃度下才有效,并且有改變紡織品其他重要特性(如手感和滲透性)的傾向,因此仍然不建議將其作為與合成抗菌聚合物同等水平的商業(yè)整理劑。
各種具有抗菌活性的天然染料和提取物也被用于紡織品整理。天然染料和提取物的抗菌性能在很大程度上取決于化學(xué)結(jié)構(gòu)和官能團(tuán),以及其成分中是否存在單寧酸(一種天然多酚)。與商業(yè)合成抗菌劑(96.2%~98.4%)相比,以海鷗果(gull nut, Quercus infectoria)為原料的天然染料顯示出更高的微生物菌落形成單位減少率(97.4%~99.5%)。此外,其他許多天然染料,如姜黃(Curcuma longa)、石榴(Punica granatum)、阿瑪拉(Mallotus philippinensis)、刀豆(Acacia catechu)、櫻桃李(Terminalia chebula)和松果,在用于棉花和羊毛等紡織材料時(shí)顯示出抗菌性能。使用媒染劑(金屬鹽)使天然染料的耐久性和抗菌性能進(jìn)一步提高。除了染料之外,各種天然提取物和聚合物,如印楝(Azadirachta indica)、蘆薈(Aloe barbadensis)、銀杏(Ginkgo biloba)、海藻酸鹽、肉桂精油和蜂膠,也被有效地用于紡織品的抗菌整理。
但使用天然化合物的主要問題是它們的初始成分,因?yàn)樗鼈兺ǔJ歉鞣N元素的復(fù)雜混合物,而且從不同來源收集的成分也不同。此外,對于天然聚合物來說,抑制微生物所需的濃度通常很高,因此紡織品的其他特性也可能被改變。因此,天然材料與合成聚合物的組合,如海藻酸/QAC、殼聚糖/AgNP和殼聚糖/ZnONP,也被認(rèn)為是抗菌整理劑,并且顯示出積極的效果。
四、紡織品抗菌性能的測試方法
有幾種標(biāo)準(zhǔn)方法可用于測試紡織品的抗菌性能。這些技術(shù)允許微生物在紡織品基質(zhì)的存在下生長,然后評估基質(zhì)對特定微生物的電阻率(使用真菌、細(xì)菌或病毒)。雖然有紡織品抗真菌、抗菌和抗病毒測試的標(biāo)準(zhǔn),但由于真菌和細(xì)菌對紡織品的物理和化學(xué)性能影響較大,所以前兩者被廣泛采用。
這些測試方法可以分為定性和定量的測試方法。定性方法提出了一種快速、簡便的方法來確定抗菌活性,特別是當(dāng)測試樣品數(shù)量大且需要篩選時(shí),而定量方法一般有煩瑣的過程,需要消耗大量的材料。
定性測試方法也被稱為瓊脂擴(kuò)散法,因?yàn)樵趯?shí)驗(yàn)過程中,紡織材料被放置在含有細(xì)菌細(xì)胞營養(yǎng)瓊脂板上。ISO 20645:2004、AATCC 147:2004和JIS L 1902:2008是一些著名的瓊脂擴(kuò)散試驗(yàn)的例子。在ISO 20645方法中,測試樣品被放置在兩層瓊脂板之間,其中上層接種了微生物,下層僅由瓊脂組成。在JIS L 1902方法中,測試樣品放在含有微生物細(xì)胞的一層瓊脂上,而在AATCC 147方法中,在將測試樣品放置在瓊脂上之前,瓊脂層上劃有微生物。這些方法通過觀察測試樣品上的光暈形成,即微生物不生長的地方來測量抗菌活性。盡管更大的光環(huán)尺寸可能是更高的抗菌性能的標(biāo)志,但通常不使用這些方法進(jìn)行量化。
抗菌活性測試的定量方法也被稱為吸收或懸浮試驗(yàn)。這些方法可以根據(jù)微生物生長的減少量提供抗菌性能的數(shù)值。一般來說,在定量方法中,細(xì)菌接種體被直接放在測試樣品上,導(dǎo)致所有液體吸附在紡織材料上。培養(yǎng)一段時(shí)間后,通過連續(xù)稀釋將細(xì)菌從測試樣本中去除,并確定細(xì)菌總數(shù)。測試樣品的抗菌性能是以與未用抗菌劑處理(完成)的對照樣品相比,細(xì)菌減少的百分比來計(jì)算的。ISO 20743:2007、JIS L 1902:2008和AATCC 100:2004是一些常見的定量方法的例子,通常用于測試紡織品的抗微生物特性。
五、等離子體處理
(一)等離子的功能
等離子體由高濃度的活性物質(zhì)組成,能夠改變聚合物表面的物理化學(xué)特性。由于等離子體不同于固體、液體或蒸汽狀態(tài),因此其被稱為物質(zhì)的第四狀態(tài)。等離子體狀態(tài)是通過對中性氣體施加能量實(shí)現(xiàn)的,如加熱或暴露于電磁場中。因此,各種活性物質(zhì)的準(zhǔn)中性混合物,如電子、離子、中子、自由基、光子、受激分子和可轉(zhuǎn)移原子,以高能量產(chǎn)生。因此,當(dāng)?shù)入x子體被引導(dǎo)到一個(gè)材料的表面時(shí),它解離了表面上的化學(xué)鍵的范圍(通常在深度小于10 nm處),從而改變了其功能。此外,等離子體的應(yīng)用會產(chǎn)生各種同步重組機(jī)制,可以通過接枝或涂層在紡織品表面沉積聚合物層。使用等離子體處理的紡織品表面的功能特性和聚合物接枝的示意圖如圖3所示。

圖3. 實(shí)現(xiàn)功能特性(a)和聚合物在紡織品表面接枝(b)的示意圖。(i)等離子體處理期間;(ii)等離子體處理之后。
通過選擇合適的氣體或氣體組合(主要是O2、H2、N2、NH3、空氣和惰性氣體),并選擇正確的等離子體參數(shù)(如壓力、能量、時(shí)間和氣體流速),可以實(shí)現(xiàn)紡織品表面性質(zhì)的明確改變。例如,正確選擇等離子體參數(shù)和處理?xiàng)l件可以改善材料的潤濕性、化學(xué)反應(yīng)性、耐化學(xué)性和力學(xué)性能以及黏附性能。根據(jù)等離子體環(huán)境和參數(shù),在紡織基材上通常會觀察到四個(gè)關(guān)鍵現(xiàn)象(同時(shí)發(fā)生且相互關(guān)聯(lián)):蝕刻、鏈裂解、自由基的形成和聚合物沉積。
蝕刻是在非常狹窄的范圍內(nèi)(即幾百埃)消除紡織品表面的顆粒,而不改變整體特性。這種現(xiàn)象也與聚合物在紡織品上的沉積有關(guān),因?yàn)槲g刻的顆粒在等離子體環(huán)境中被電離并沉積在表面,因此它們會繼續(xù)進(jìn)行重組?;钚晕镔|(zhì)與紡織品表面的分子的碰撞導(dǎo)致鏈的裂解和原子的提?。ㄍㄟ^蝕刻)。此外,當(dāng)?shù)入x子體自由基與表面自由基相互作用時(shí),會在表面產(chǎn)生新的基團(tuán),使表面變得功能化[圖3(a)]。此外,鏈交聯(lián)是通過自由基的重組發(fā)生的。當(dāng)整理聚合物(如抗菌整理)被引入等離子體室時(shí),通過等離子體自由基的同時(shí)交聯(lián),聚合物被嫁接到紡織基材上[圖3(b)]。
(二)紡織品加工中使用的等離子體
等離子體可以在高溫或低溫下應(yīng)用。因?yàn)榇蠖鄶?shù)紡織纖維對熱敏感,所以只有低溫等離子體(也被稱為冷等離子體)被應(yīng)用于紡織品。等離子體處理可以使用低頻(1~500 kHz)、射頻(RF)(常用13.56 MHz或27.12 MHz)和微波(常用915 MHz或2.45 GHz)能量通過直流(DC)或交流(AC)進(jìn)行。
等離子體既可以在密閉室中的低壓下產(chǎn)生,也可以在大氣壓下產(chǎn)生。低壓(1~100 Pa)等離子體通常使用射頻或微波能量來應(yīng)用。盡管這種技術(shù)可以產(chǎn)生均勻的效果,并且對紡織品具有良好的可重復(fù)性,同時(shí)消耗少量的氣體,但由于樣品的大小受限于封閉室的大小,因此很難適應(yīng)大規(guī)模連續(xù)生產(chǎn)的紡織品。因此,等離子體在大氣條件下的應(yīng)用被認(rèn)為對連續(xù)的紡織生產(chǎn)線生產(chǎn)更實(shí)用。
如圖4所示,四種類型的常壓等離子體通常用于紡織品,即電暈放電(CD)、介質(zhì)屏障放電(DBD)、常壓輝光放電(APGD)和常壓等離子體噴射(APPJ),具體如表2中所列。在CD方法中,使用的電極不同:一種是針狀的,另一種是圓柱體或片狀的。等離子體存在于針尖附近的擴(kuò)展氣體區(qū)域,稱為電離區(qū)。等離子體物質(zhì)向另一個(gè)電極擴(kuò)散,產(chǎn)生一個(gè)漂移區(qū)域[圖4(a)]。兩個(gè)電極之間的距離通常非常小,適用于薄的紡織品。但這種方法中的電離是非常弱的,并且對表面的影響是不均勻的。因此,目前CD在紡織品中的應(yīng)用非常有限。
表2 紡織品加工中大氣等離子體處理的常用方法


圖4. 紡織品上不同常壓等離子體處理的示意圖。(a)CD;(b)DBD;(c)APGD;(d)APPJ。
DBD是一種升級的技術(shù)(與CD相比),絕緣材料被相隔2~5 mm的兩個(gè)電極中的至少一個(gè)所覆蓋[圖4(b)]。普通DBD技術(shù)的應(yīng)用電壓約為20 kV(AC)。盡管可能出現(xiàn)兩種形式的DBD,即均勻的或絲狀的,但通過仔細(xì)選擇處理?xiàng)l件,可以實(shí)現(xiàn)均勻和均質(zhì)的表面處理。第三種技術(shù),即APGD,通常在高頻率(2~60 MHz)和低電壓(約200 V)下進(jìn)行,使用兩個(gè)裸露的電極(未涂覆金屬),電極間的距離為幾毫米[圖4(c)]。雖然這種技術(shù)通常能在紡織品上產(chǎn)生均勻和均質(zhì)的效果,但其缺點(diǎn)是必須使用昂貴的氦氣以避免在電極之間形成電弧。為了抵消這個(gè)問題,有時(shí)會使用其他氣體(如Ar和N2)作為替代品。最后,APPJ技術(shù)是最近加入的,其中兩個(gè)電極以同心的方式放置[圖4(d)]。氣體通過電極,施加的能量(RF, 100~250 V)將氣體轉(zhuǎn)化為等離子體。然后,等離子體通過一個(gè)噴嘴向紡織基材的表面流出。APPJ技術(shù)可以均勻地應(yīng)用于任何形狀的紡織品。
除了上面提到的那些,還有一些其他類型的等離子體應(yīng)用技術(shù)常用于紡織品整理,包括氣相沉積和電感耦合等離子體。等離子體氣相沉積是將連續(xù)的氣相投射到紡織品基材上,以實(shí)現(xiàn)薄膜層。在紡織工業(yè)中,這種薄層大多是通過在磁場存在下的等離子體濺射沉積(也稱為磁控濺射沉積系統(tǒng))實(shí)現(xiàn)的[圖5(a)]。紡織基材放在陽極上,用陰極夾住金屬或合金目標(biāo)。在陰極附近放置與目標(biāo)平行的磁場以捕獲目標(biāo)附近的電子。通常,氬氣(Ar)被用于此目的;Ar隨著能量的應(yīng)用而被分解,形成異常的輝光放電。磁場的存在增加了等離子體密度和擊中目標(biāo)的濺射原子的數(shù)量,從而在紡織基材上產(chǎn)生了更高的沉積。
另一種類型的等離子體,即電感耦合等離子體,可以是圓柱形的[圖5(b)],也可以是平面的[圖5(c)],通常由射頻能量驅(qū)動。圓柱形是由初級線圈的軸向靜電場或電磁場維持的。但在平面線圈系統(tǒng)中,從軸線到外半徑都是一個(gè)扁平的螺旋線,外面使用多極磁鐵來加強(qiáng)向外的等離子體的均勻性。雖然電感耦合等離子體可以在低壓或常壓下使用,但以前的研究大多采用低壓條件,以達(dá)到更高的等離子體密度。

圖5. 磁控濺射沉積系統(tǒng)(a)及使用射頻能量的圓柱形(b)和平面幾何形狀(c)的電感耦合等離子體的示意圖。
(三)評估等離子改性的紡織品特征
通過等離子體處理評估紡織品改性的常見方法包括物理和化學(xué)分析。等離子體的應(yīng)用通常在很窄的深度上破壞紡織品的表面(通常稱為等離子體蝕刻)。這可以通過紡織物表面的形態(tài)分析來觀察,如掃描電子顯微鏡(SEM)圖像。但由于表面的變化是名義上的,有時(shí)在SEM圖像中無法察覺。在這種情況下,分析表面形貌的其他技術(shù)是有用的,如掃描探針顯微鏡,可以提供表面粗糙度的數(shù)值。
紡織品經(jīng)等離子體處理后的化學(xué)變化主要取決于紡織品本身的化學(xué)結(jié)構(gòu)和使用的等離子體氣體。不同的等離子體氣體可以通過引入新的化學(xué)基團(tuán)在紡織品表面產(chǎn)生不同的功能。例如,含氧(O2)的等離子體可以在纖維素纖維上產(chǎn)生新的C——O或O—C—O基團(tuán),而含氮的等離子體可以產(chǎn)生C—N或O——C——NH基團(tuán)。含氟氣體(如C2F6、C3F6和SF6)經(jīng)常被用來在紡織基材上產(chǎn)生一個(gè)薄的疏水層?;瘜W(xué)結(jié)構(gòu)的變化可以用各種技術(shù)來研究,包括傅里葉變換紅外光譜(FTIR)和X射線光電子能譜(XPS)。在紡織品上應(yīng)用等離子體會影響其表面能量、潤濕性和顏色(由蝕刻引起的標(biāo)稱變化,改變了光的反射模式)。因此,紡織品上的等離子體修飾也經(jīng)常通過研究表面的亮度、表面能測量和毛細(xì)管高度測量來評估。
六、等離子體處理在紡織品抗菌整理中的應(yīng)用
(一)抗菌化合物的接枝和聚合
與墊干固化等普通工藝不同,在紡織品上接枝各種化合物時(shí),等離子體處理可以激活基材和單體,誘導(dǎo)接枝反應(yīng),無需加熱或浸泡在化學(xué)浴中,從而減少了水和能源的消耗,將環(huán)境污染降到最低??删酆系那绑w,如乙烯基、芳香族、環(huán)狀和飽和碳?xì)浠衔锘蚪饘儆袡C(jī)化合物,可以在等離子體的幫助下直接在基材表面聚合。如果在等離子體室中不能直接使用可聚合的前體,可以使用活性氣體(如O2或N2)或非活性氣體(如Ar和He)進(jìn)行表面活化。在等離子體介質(zhì)中存在的高能物種與基材的聚合鏈碰撞過程中,表面會產(chǎn)生自由基。乙烯基單體可以與等離子體產(chǎn)生的自由基反應(yīng),并在活化的基質(zhì)上進(jìn)行接枝聚合。通常情況下,紡織基材的表面被等離子體激活,表面上產(chǎn)生自由基。然后,通過浸漬、填充或噴涂的方法使被激活的基材受到乙烯基單體溶液的影響。加熱等離子體處理過的基材,單體處理過的基材可以提高接枝的產(chǎn)量。通過填充、蒸發(fā)或噴涂將單體沉積在紡織基材上,使該過程能夠與常壓等離子體處理連續(xù)進(jìn)行,從而減少化學(xué)品、能源和時(shí)間的消耗。
含有乙烯基的QAC可以用等離子體嫁接到紡織纖維上,并具有抗菌功能。等離子體處理會在纖維的表面產(chǎn)生自由基。最初形成的自由基暴露在O2或空氣中時(shí),會形成過氧自由基,這就引發(fā)了乙烯基單體在基材上的接枝聚合。加入莫爾鹽[Fe(NH4)2(SO4)2·6H2O]可以防止溶液中的均聚作用,增加接枝率。Cornelius等采用大氣等離子體(DBD和APPJ)將(3-丙烯酰胺丙基)三甲基氯化銨(作為乙烯基QAC)接枝到聚丙烯(PP)和棉無紡布上。過程的順序是等離子體—襯墊—干燥—等離子體。XPS、SEM和酸性染料吸附實(shí)驗(yàn)都證實(shí)了接枝的效果。接枝過程的機(jī)制如圖6所示。這個(gè)過程在不需要使用熱溶劑或濕溶劑的情況下,得到了高的接枝率和均勻性。

圖6. 由DBD等離子體引發(fā)的(3-丙烯酰胺丙基)三甲基氯化銨在PP非織造布上的接枝機(jī)制示意圖。HV:高電壓。
二烯丙基二甲基氯化銨(DADMAC)通過APGD等離子體(99% He/1% O2)的預(yù)活化和后處理被嫁接到PP無紡布上。樣品經(jīng)過一個(gè)過程,包括等離子體預(yù)活化、用DADMAC和季戊四醇四丙烯酸酯(作為交聯(lián)劑以增加涂層的耐久性)進(jìn)行填充、干燥、等離子體誘導(dǎo)接枝聚合和漂洗的過程。等離子體誘導(dǎo)接枝聚合的過程和自由基機(jī)制如圖7所示。通過SEM、FTIR和飛行時(shí)間二次離子質(zhì)譜(TOF-SIMS)證實(shí)了聚DADMAC在PP纖維上的嫁接。在優(yōu)化條件下制備的樣品對金黃色葡萄球菌(S.aureus)和肺炎克雷伯菌(K. pneumoniae)顯示出良好的抗菌活性。同樣的過程被應(yīng)用于尼龍/棉(50%/50%)混紡面料,據(jù)報(bào)道細(xì)菌生長減少了99.9%。由于高程度的交聯(lián),用這種方法制備的抗菌涂層具有高耐久性。

圖7. 等離子體誘導(dǎo)接枝聚合的示意圖。(a)等離子體激活DADMAC在PP非織造布上的附著過程;(b)附著機(jī)理。
Arik等研究了Ar DBD等離子體處理(130 W, 40 s)對使用基于Ag、二氯苯酚、三氯生和二苯基烷衍生物的商業(yè)抗菌產(chǎn)品的棉花整理的影響,使用的是墊干式固化程序。能量色散X射線能譜(EDX)結(jié)果證實(shí),等離子體處理過的棉花中的銀含量高于未處理過的樣品。通過等離子體處理,其抗菌活性和耐久性得到明顯改善,對二苯基烷烴衍生物的負(fù)載和耐久性更有效。
等離子體處理可以增強(qiáng)殼聚糖在紡織纖維上的吸附和附著。Naebe等使用氦氣和He/O2常壓等離子體,使用墊干固化工藝將殼聚糖附著在棉織物上。等離子體處理后,殼聚糖涂層的表面能和厚度得到了改善。整理后的成品織物對革蘭氏陰性大腸桿菌(E. coli)表現(xiàn)出明顯的抗菌活性[圖8(a)]。但結(jié)果表明,單獨(dú)的等離子體處理和沒有任何進(jìn)一步的殼聚糖涂層也能夠降低細(xì)菌的活性(圖8),因?yàn)樾纬闪嘶钚晕镔|(zhì),如氦亞穩(wěn)態(tài)物種(He*)、O和OH。黏膠織物的低壓氧等離子體處理(800 W, 27.12 MHz, 75 Pa, 30 s)提高了殼聚糖的負(fù)載量,并賦予成品織物良好的抗菌活性。Haji等表明,O2等離子體處理增強(qiáng)了殼聚糖在棉和羊毛纖維上的附著,并改善了織物的染色性和抗菌活性。DBD等離子體增加了PET織物表面的含O2基團(tuán)的數(shù)量,并通過浸泡在乙酸殼聚糖溶液[2% (w/V)]和真空干燥增強(qiáng)了殼聚糖的沉積。殼聚糖涂層樣品對大腸桿菌和金黃色葡萄球菌顯示出高的抗菌活性[圖8(b)]。當(dāng)使用墊烤程序?qū)r/O2等離子體處理過的PET樣品涂上殼聚糖聚合物和低聚物時(shí),也得到了類似的結(jié)果。以空氣作為處理氣體,用功率為1000 W的APPJ對尼龍織物進(jìn)行活化,改善了殼聚糖在織物上的接枝,提高了涂層織物的抗菌活性。兩種類型的殼聚糖,即殼聚糖低聚物(Mw = 12 000 Da)和殼聚糖聚合物(Mw = 170 000 Da),被用于接枝。經(jīng)等離子體處理的織物立即在殼聚糖溶液中浸漬6 min,并在95 ℃下固化8 min,然后進(jìn)行清洗。通過XPS分析證實(shí)了表面活化、引入新的含O2基團(tuán)以及將殼聚糖接枝到尼龍纖維上。接枝了殼聚糖聚合物的織物樣品比接枝了低聚物的樣品顯示出更高的抗菌活性。通過等離子體后處理,抗菌活性和親水性得到進(jìn)一步提高?;跉ぞ厶堑目咕韯┑目咕钚匀Q于分子量、殼聚糖的脫乙酰化程度和介質(zhì)的pH值。盡管殼聚糖具有廣泛的抗菌譜,但其效率在堿性pH值下會降低。通過對殼聚糖進(jìn)行化學(xué)修飾,引入永久性的正電荷,可以提高其抗菌活性,而不受介質(zhì)的pH值影響。
圖8. (a)(i)0 h后僅接種物,(ii)1 h后僅接種物,(iii)對照棉織物,(iv)殼聚糖處理的棉織物,(v)氦氣等離子體處理的棉織物,(vi)氦氣等離子體/殼聚糖處理的棉織物,(vii)He/O2等離子體處理的棉織物,(viii)He/O2等離子體/殼聚糖處理的棉織物的抗菌活性;(b)DBD等離子體/殼聚糖處理的聚酯織物。DD:脫乙?;某潭?。經(jīng)Springer Nature ©2016、2010許可,轉(zhuǎn)載自參考文獻(xiàn)。
胍基抗菌劑因其陽離子特性而具有良好的抗菌和生物殺滅作用,它與細(xì)菌或生物體細(xì)胞膜產(chǎn)生靜電相互作用,導(dǎo)致其死亡。Yim等使用DBD系統(tǒng),通過常壓等離子體增強(qiáng)化學(xué)氣相沉積(AP-PECVD)工藝在超高分子量聚乙烯(UHMWPE)薄膜上沉積1,1,3,3-四甲基胍(TMG)。前體水溶液被加熱到25 ℃,用氦氣作為載氣將蒸汽轉(zhuǎn)移到電極之間的空間。等離子體處理在330 W下進(jìn)行30~180 s(90 kHz)。通過SEM、原子力顯微鏡(AFM)、衰減全反射(ATR)-FTIR和XPS分析,證實(shí)了表面有島狀胍聚合物的涂層。在最佳條件下涂布的樣品顯示大腸桿菌和金黃色葡萄球菌的生長完全減少。這種工藝的優(yōu)點(diǎn)是胍類化合物的陽離子和堿性性質(zhì)導(dǎo)致其在所有pH值范圍內(nèi)都具有抗菌活性。表3提供了通過各種等離子體處理技術(shù)在各種紡織纖維上實(shí)現(xiàn)的抗菌整理的總體比較。
(二)通過表面活化提高抗菌劑的負(fù)載
通過等離子體處理進(jìn)行表面活化或功能化被認(rèn)為是一種快速和經(jīng)濟(jì)的預(yù)處理過程,可促進(jìn)紡織品基材上不可聚合的抗菌劑的負(fù)載。通常,QAC、納米顆粒和藥物等抗菌劑在紡織品上的負(fù)載和牢度性能較低,尤其是那些由疏水性纖維制成的紡織品。需要進(jìn)行表面處理以改善紡織纖維的潤濕性、表面張力和反應(yīng)活性。
QAC具有熱穩(wěn)定性、低人體毒性和氧化性(不會惡化紡織品的物理性能)等優(yōu)點(diǎn),使得這些化合物在紡織品表面的抗菌整理中得到了廣泛的應(yīng)用,而且成本低、殺菌效果好。Song等采用DBD等離子體處理來改善作為QAC的烷基二甲基芐基氯化銨(ADBAC)與棉、PET和棉/PET濕巾之間的相互作用。DBD等離子體處理增加了ADBAC在PET和棉/PET濕巾上的吸附,因?yàn)槠浔砻媾c等離子體產(chǎn)生的含O2基團(tuán)相互作用。盡管ADBAC在未經(jīng)處理的棉樣上的吸附量高于未經(jīng)處理的PET和棉/PET樣品,但經(jīng)過DBD等離子體處理后,棉表面的ADBAC含量有所下降,這可能是由于ADBAC在纖維內(nèi)部的滲透。因此,與其他織物相比,經(jīng)等離子體處理的PET樣品顯示出最高的抗菌活性,因?yàn)樗谋砻嫔嫌凶罡邼舛鹊腁DBAC。由于大部分ADBAC滲透到親水棉纖維中,降低了其在表面的濃度,因此經(jīng)過等離子體處理過的棉布樣品的抗菌活性處于最低水平??偟膩碚f,DBD等離子體處理改善了抗菌活性,并延長了含PET濕巾的抗菌功效的保質(zhì)期。

圖9. 未經(jīng)處理(R)和等離子處理(P)擦拭樣品的細(xì)菌對數(shù)減少。W1~W3分別是純聚酯、纖維素/聚酯(55%/45%)和100%漂白棉的樣品。經(jīng)Elsevier Ltd. ©2019許可,轉(zhuǎn)載自參考文獻(xiàn)。
表3 在不同紡織纖維上進(jìn)行抗菌整理的常見等離子體處理技術(shù)和報(bào)道的結(jié)果




為了提高用于疝氣修復(fù)的PP網(wǎng)片上作為抗菌劑的氨芐西林的負(fù)荷,PP纖維的表面通過四乙二醇二甲醚的等離子體聚合進(jìn)行了功能化。采用低壓射頻等離子體,使用Ar作為載氣。該過程是由一個(gè)簡短的預(yù)激活步驟開始的,使用Ar等離子體在100 W的條件下進(jìn)行30 s。然后,通過在液體單體中鼓泡Ar,將四乙二醇二甲醚蒸氣引入等離子體室。聚合是在壓力為40 Pa、功率為200 W的情況下進(jìn)行的,時(shí)間為2 h。通過將等離子體聚合的樣品浸泡在4%的氨芐青霉素水溶液中24 h,然后進(jìn)行填充和干燥來進(jìn)行氨芐青霉素的負(fù)載。修飾過的PP網(wǎng)片上的氨芐西林的負(fù)載量比未處理的樣品高3倍,樣品對金黃色葡萄球菌和大腸桿菌顯示出抗菌活性。這個(gè)過程導(dǎo)致了高的藥物負(fù)載,而成纖維細(xì)胞的特性,如趨化性、黏附性和形態(tài)保持不受影響。
Ivanova等使用包括等離子體處理和噴墨打印的連續(xù)工藝,將含有辛烯酸的聚(L-乳酸)(PLLA)聚合物納米顆粒作為抗菌劑應(yīng)用于PET和PP無紡布上。簡而言之,織物樣品用常壓空氣等離子體進(jìn)行預(yù)處理,然后用噴墨打印機(jī)印上抗菌納米粒子。等離子體處理改善了納米顆粒在織物表面的潤濕性、分布和擴(kuò)散。這個(gè)過程是連續(xù)的,并有可能通過廉價(jià)、簡單、快速和全自動的程序來制備抗菌紡織品。
DBD處理改善了低濃度(10 mg?L-1)的聚乙烯吡咯烷酮(PVP)涂層AgNP在聚酰胺66織物上使用噴霧和排氣方法的沉積。30 ℃的排氣法顯示出最好的效果,AgNP在等離子體處理過的織物上的抗菌效果在五個(gè)洗滌周期后仍然沒有改變。等離子體處理增加了聚酰胺纖維的粗糙度,并在表面產(chǎn)生了新的官能團(tuán),從而使其更好地吸附和黏附AgNP。這種方法的優(yōu)點(diǎn)是使用非常少量但有效的AgNP進(jìn)行抗菌整理。Zille等也研究了DBD等離子體處理和老化對不同尺寸的AgNP的負(fù)載和聚酰胺66織物的抗菌活性的影響。結(jié)果表明,含氧化學(xué)物質(zhì)的形成促進(jìn)了納米粒子與尼龍纖維之間的離子鍵和共價(jià)鍵,從而增加了等離子體處理后的粗糙度、表面能和潤濕性。未經(jīng)處理和等離子體處理的聚酰胺織物都顯示出很高的抗菌活性,即使是在30天的老化之后。等離子體處理促使AgNP的吸附量增加了三倍,并提高了涂層的耐久性。AgNP的裝載量隨著粒徑的減小而增加。對用顆粒大小在10~100 nm范圍內(nèi)的AgNP涂層的等離子體處理過的樣品的抗菌活性進(jìn)行比較,結(jié)果顯示使用40~60 nm的AgNP時(shí),其功能最高且最持久。這是一個(gè)優(yōu)勢,因?yàn)檩^小的AgNP具有較高的毒性。用低壓空氣等離子體(27 Pa, 100 W, 2.5 min)進(jìn)行表面活化,增強(qiáng)了膠體AgNP在PET織物上的結(jié)合效率、抗菌活性和穩(wěn)定性。盡管經(jīng)過五個(gè)洗滌周期后,抗菌活性仍然持久,但銀仍被釋放到洗滌槽中。
Nourbakhsh報(bào)道,棉的電暈處理增加了羧基含量,改善了對硝酸銀溶液中銀離子的吸附,并提高了織物的抗菌活性和耐洗牢度。電暈預(yù)處理也改善了涂有Cu和ZnO納米顆粒的棉織物的自清潔和抗菌活性。用常壓空氣等離子體對竹子織物進(jìn)行預(yù)處理增強(qiáng)了AgNP的負(fù)載。在這項(xiàng)研究中,將等離子體處理過的竹子織物浸泡在含有硝酸銀和檸檬酸三鈉的浴液中,并使用微波加熱3 min在纖維上合成AgNP。在竹纖維表面合成AgNP,改善了紫外線防護(hù),增加了水接觸角。棉花的低壓四氟甲烷(CF4)等離子體處理(40 Pa, 27.12 MHz, 1200 W, 10 s)在表面引入了C——O、O—C—O、C—O和O——C—O基團(tuán),增加了粗糙度。通過XPS分析,證實(shí)在表面沒有觀察到含氟(F)的基團(tuán)。CF4等離子體處理增強(qiáng)了AgNP(30 nm)的負(fù)載,成品棉織物顯示出良好的抗菌活性。
Anjum等通過向1%的聚乙二醇溶液中滴加1000 ppm的硝酸銀溶液,并在60 ℃下攪拌15~120 min,制備了一種納米Ag負(fù)載凝膠。合成的納米顆粒的粒徑范圍為10~50 nm。二氧化碳等離子體(60 s, 40 W)被用于PET單絲縫合線的功能化,然后再附著AgNP和洗必泰(葡萄糖酸氯己定)。等離子處理增加了PET長絲表面的羧基含量。將經(jīng)過等離子體處理的樣品在25 ℃下浸泡在所制備的AgNP負(fù)載的凝膠或1%的洗必泰水溶液中2 h,然后清洗并在真空下干燥。與對照樣品相比,所制備的縫合線顯示出良好的抗菌和愈合性能。
Radi?等比較了兩種類型的常壓等離子體處理對非織造布上的金納米顆粒沉積的影響。通過使用沒食子酸還原Au3+ (HAuCl4, 1 mmol·L-1)來制備AuNP。使用空氣作為處理氣體的DBD和擴(kuò)散共面表面阻擋放電(DCSBD)被應(yīng)用于非織造布PP的表面活化。等離子體處理系統(tǒng)的配置如圖10所示。在DBD設(shè)置中,沸石顆粒被用在接地電極上,以吸附濕度并確保均勻放電。電感耦合等離子體原子發(fā)射光譜(ICP-AES)顯示,DBD和DCSBD等離子體處理都增加了PP纖維上沉積的AuNP的數(shù)量。在DBD處理和DCSBD處理的樣品中,金納米顆粒的含量分別是未處理樣品的4倍和3倍。當(dāng)用DCSBD預(yù)處理12 s (24 J?cm-2)或DBD預(yù)處理120 s (14.4 J?cm-2)并涂上AuNP時(shí),PP樣本的抗菌活性最好。使用圖10所示的DBD裝置對黏膠織物進(jìn)行空氣等離子體預(yù)處理,增加了織物對Cu2+和Ag+的吸收,從而提高了成品的抗菌活性。等離子處理后和Ag離子負(fù)載7天前的樣品老化,使Ag+的加載量增加到100%。如上所述,用DBD等離子體預(yù)處理棉/滌綸織物時(shí),所得樣品的Ag離子負(fù)載和抗菌活性都有所提高。

圖10. DBD和DCSBD常壓等離子體系統(tǒng)的配置。
盡管在應(yīng)用納米顆粒之前對紡織品表面進(jìn)行等離子體處理可以改善其黏附性,但將納米顆粒納入聚合物基體可以進(jìn)一步改善納米顆粒的穩(wěn)定性。等離子體聚合物是通過單體在氣體或液體狀態(tài)下的等離子體聚合而產(chǎn)生的。等離子體聚合物的厚度、孔隙率和硬度可以通過調(diào)整工藝參數(shù)輕松控制,金屬離子(如Ag離子)的釋放行為可以通過在等離子體聚合物中嵌入納米顆粒得到充分控制。
Irfan等通過在纖維表面同時(shí)濺射AgNP和等離子體沉積六甲基二硅氧烷(HMDSO)對棉織物進(jìn)行功能化。在優(yōu)化條件下沉積的復(fù)合薄膜可制備出具有抗菌活性的高疏水性棉織物,該織物在10次洗滌過程中都很穩(wěn)定。在另一項(xiàng)研究中,首先使用O2/N2等離子體將HMDSO聚合在PET無紡布的表面,以獲得厚度為70 nm的有機(jī)硅涂層。然后,將樣品浸入不同Ag、Cu和ZnO納米顆粒在乙醇中的懸浮液中1 min,并進(jìn)行干燥。最后,如前所述,又沉積了一層厚度為10 nm的有機(jī)硅涂層。Ag和Cu涂層的樣品顯示出很高的抗菌活性,而ZnO涂層的樣品的抗菌活性略低,這是由于所使用的ZnO納米顆粒的尺寸較大。第二個(gè)有機(jī)硅層作為一個(gè)屏障,防止納米顆粒的脫離和不受控制的釋放,涂有該層的樣品顯示出納米顆粒的持久釋放,在10個(gè)洗滌周期后仍然穩(wěn)定。
利用一種新型的APPJ將Ag顆粒濺射到棉織物上以獲得抗菌涂層。該裝置由放置在兩個(gè)玻璃管中的兩個(gè)Ag電極組成。O2和Ar的混合物通過電極,并對其施加高電壓(15 kV, 450 W)。棉布和噴嘴之間的距離是5 mm。APPJ裝置示意圖如圖11所示。

圖11. 為濺射Ag而設(shè)計(jì)的APPJ裝置的示意圖。
光學(xué)發(fā)射光譜證實(shí)了等離子體濺射的Ag,而SEM圖像證實(shí)了Ag顆粒沉積在棉花樣品上。所制備的樣品對革蘭氏陽性和革蘭氏陰性細(xì)菌顯示出抗菌活性,并且抑制區(qū)隨著處理時(shí)間的延長而增加。
常壓直流輝光放電等離子體處理莫代爾織物,改善了ZnONP的涂層,增強(qiáng)了織物的抗菌活性。FTIR分析顯示,O2和空氣等離子體處理在模態(tài)纖維表面產(chǎn)生了C——O和—OH基團(tuán),導(dǎo)致水接觸角下降,并提高了ZnONP的負(fù)載。Jazbec等的研究表明,用400 W的低壓電感耦合射頻O2等離子體處理棉織物10~30 s,增加了棉纖維的表面官能團(tuán)和粗糙度,從而使ZnONP的負(fù)載更好,并增強(qiáng)了防紫外線(UV)性能。由于等離子體蝕刻導(dǎo)致紗線和纖維之間的摩擦力增加,樣品的斷裂強(qiáng)度和斷裂伸長率在等離子體處理后也得到改善。
Zhou等使用墊干式等離子體固化方法將5,5-二甲基海因(DMH)應(yīng)用于棉織物。成品織物使用次氯酸鈉進(jìn)行氯化處理,將DMH的酰胺基團(tuán)轉(zhuǎn)化為N-鹵胺,可以殺死細(xì)菌。常壓He/N2等離子體處理提高了對金黃色葡萄球菌的抗菌活性的耐久性,并且所賦予的抗菌活性是通過氯化作用產(chǎn)生的。DMH氯化反應(yīng)如圖12所示。

圖12. 使用He/N2等離子體和NaClO的氯化作用使DMH附著在棉花上的機(jī)制。
等離子體預(yù)處理可以提高天然抗菌提取物在紡織品上的負(fù)載。Kongarasi等的研究表明,當(dāng)用兩種草藥提取物,即蘆薈葉和大馬士革玫瑰花的組合進(jìn)行整理時(shí),低壓空氣等離子體處理增強(qiáng)了竹纖維織物的抗菌和抗真菌效率及耐久性。與水、氯仿和石油醚提取物相比,乙醇提取物顯示出最高的抗菌活性。在25次洗滌循環(huán)后,其抗菌活性得以保持。在另一項(xiàng)研究中,用綠茶(Camellia sinensis)和圖爾西(Ocimum sanctum)葉提取物整理時(shí),空氣DBD等離子體處理4 min,改善了潤濕性,增加了香蕉纖維上的表面極性基團(tuán),并增強(qiáng)了香蕉織物的抗菌活性和耐久性。棉花的低壓O2和N2等離子體處理改善了棉織物上百里酚的負(fù)載,并賦予樣品極大的抗菌活性,這些樣品在50個(gè)洗滌周期內(nèi)都很穩(wěn)定。負(fù)載百里酚的棉質(zhì)樣品在未經(jīng)等離子體激活的情況下,其抗菌活性在5個(gè)洗滌周期內(nèi)是穩(wěn)定的。
低壓射頻空氣等離子體預(yù)處理改善了棉織物的潤濕性,增強(qiáng)了印楝樹葉提取物作為天然抗菌劑的吸收能力。提取物與檸檬酸作為交聯(lián)劑,采用墊干固化工藝進(jìn)行應(yīng)用。當(dāng)樣品在50 W的功率下被等離子體處理5 min,而電極之間的距離為3 cm時(shí),獲得了最高的抗菌活性。用纖維素酶水解棉花也顯示了同樣的效果,當(dāng)樣品先經(jīng)過酶處理,然后再經(jīng)過等離子體處理時(shí),會出現(xiàn)協(xié)同效應(yīng)。ATR-FTIR分析證實(shí)在纖維素鏈上引入了新的羰基官能團(tuán)。圖13顯示了空氣等離子體處理期間纖維素的化學(xué)變化。用纖維素和空氣等離子體處理的棉花樣品及用印楝樹葉提取物整理的棉花樣品顯示出抗真菌活性,對革蘭氏陽性和革蘭氏陰性細(xì)菌都有100%的細(xì)菌減少。30次洗滌循環(huán)后,抗菌效果穩(wěn)定。O2等離子體顯示出比空氣等離子體稍好的結(jié)果。經(jīng)空氣等離子體處理的棉花在150 ℃下經(jīng)受印楝油蒸氣作用60 min,也顯示出良好的抗菌活性。用低壓O2等離子體預(yù)處理并用洋蔥皮和洋蔥果肉提取物染色的棉織物顯示出對金黃色葡萄球菌具有抗菌活性。

圖13. 空氣等離子體處理在纖維素上引起的化學(xué)變化。
用低壓O2等離子體對羊毛織物進(jìn)行預(yù)處理,通過以檸檬酸為交聯(lián)劑的墊干式固化工藝,增強(qiáng)了-環(huán)糊精在羊毛織物上的附著。經(jīng)過等離子體處理和-環(huán)糊精處理的羊毛織物上有小檗堿,顯示出明顯的抗菌活性??諝釪BD處理羊毛可以增強(qiáng)以天然著色劑小檗堿的羊毛可染性,在最佳條件下制備和染色的樣品對革蘭氏陽性和革蘭氏陰性細(xì)菌顯示出抗菌活性。
(三)等離子體濺射
通過直流磁控濺射在棉布上鍍上Ag納米層[基礎(chǔ)壓力:0.02 mTorr (1 mTorr = 0.133 Pa),進(jìn)料時(shí)的工作壓力Ar:0.05 Torr, 5 min],使成品織物具有抗菌和防紫外線的特性,其在10個(gè)洗滌周期后仍然穩(wěn)定。
Yuan等使用連續(xù)濺射系統(tǒng)在滌綸織物上沉積銀/二氧化鈦納米復(fù)合材料。旋轉(zhuǎn)的圓柱形Ag和Ti靶材被用作陰極。試驗(yàn)室壓力為0.006 Pa,采用直流和直流/射頻濺射方法。在直流濺射中,首先濺射的是Ag,然后是Ti。Ti濺射層在短時(shí)間暴露于空氣中后被轉(zhuǎn)化為TiO2。使用Ar/O2作為處理氣體對Ti進(jìn)行反應(yīng)性濺射時(shí),直接獲得了TiO2納米涂層。滌綸織物在結(jié)構(gòu)上被著色,濺射后的織物的物理性能略有下降。濺射涂層的織物顯示出明顯的抗菌活性,并改善了抗靜電和防紫外線性能。
在對紡織品進(jìn)行金屬濺射涂層時(shí),整個(gè)表面都被均勻的金屬薄層所覆蓋。據(jù)報(bào)道,在使用紡織品進(jìn)行傷口愈合時(shí),對整個(gè)表面進(jìn)行涂層不利于產(chǎn)品的生物相容性。Liu等在棉質(zhì)無紡布上使用PET模板,在表面濺射Ag和Zn點(diǎn),獲得高的抗菌活性,同時(shí)保留了生物相容性和加速傷口愈合的特性。通過激光燒蝕制備的PET模板被放置在棉布的上面。分別采用Ag和Zn靶材進(jìn)行濺射,使用Ar作為處理氣體[15 sccm(標(biāo)準(zhǔn)狀態(tài)下,15 cm3·min-1],功率為100 W。與單獨(dú)涂覆Ag或Zn的樣品相比,涂覆兩種金屬的樣品在傷口愈合和抗菌活性方面表現(xiàn)出協(xié)同作用。
Naeem等使用空心放電陰極等離子體系統(tǒng)在PET織物上沉積Ag以獲得抗菌性能。在空心陰極的中心使用了高純度的Ag,并在1 Pa的壓力和10 sccm的Ar流速下進(jìn)行了10~60 min的沉積。電壓為340 V,電流為0.4 mA。在不同的等離子體處理時(shí)間下,水和甘油在Ag涂層的PET織物表面的接觸角如圖14(a)所示。接觸角的增加導(dǎo)致了細(xì)菌在表面上的附著力的減少和抗菌活性的提高。圖14(b)顯示,等離子體處理時(shí)間增加到60 min后,顆粒尺寸和密度略有增加。Ag涂層樣品的抗菌活性隨著等離子體處理時(shí)間的增加而提高。

圖14. 等離子體處理時(shí)間對接觸角(a)和Ag涂層PET織物的尺寸和密度(b)的影響。
金屬或非金屬性質(zhì)的均勻和高純度的薄膜可以通過磁控濺射沉積在各種紡織材料上。通過適當(dāng)?shù)剡x擇工藝參數(shù),可以很容易地調(diào)整薄膜的厚度和與表面的黏附力。通過在紡織物上濺射選定的金屬或金屬氧化物,可以獲得不同的功能特性,包括電磁干擾(EMI)屏蔽、紫外線防護(hù)、紅外線防護(hù)、抗靜電、導(dǎo)電性、氣敏性、親水性、疏水性、結(jié)構(gòu)著色、雷達(dá)反射和改善染色。銅、銀、鈦、鋁、鉑、鋅、黃銅、氧化鋅、氧化銅、氧化鎂和二氧化鈦是通過濺射用于紡織品抗菌整理的金屬和金屬氧化物靶標(biāo)的例子。諸如激光預(yù)處理等準(zhǔn)備工作可以增強(qiáng)濺射金屬涂層與基材之間的附著力。等離子體在滌綸/絲綢織物上濺射銅40 min,使水接觸角增加到146°,并明顯降低了表面電阻率。涂層織物對大腸桿菌和金黃色葡萄球菌顯示出抗菌活性。在Ar、O2和N2作為工作氣體的情況下,使用Ti和Cu靶材在棉織品上濺射了氮氧化鈦(TiON)/Cu復(fù)合涂層。涂有TiON的棉布顯示出90%的細(xì)菌減少量,當(dāng)Cu被共濺射時(shí)達(dá)到100%。將Ag和SiO2在棉織物上射頻共濺射15~80 min,使Ag嵌入到SiO2薄膜中,并控制釋放Ag離子,這給涂層樣品帶來了很高的抗菌活性。
(四)納米顆粒的合成
納米顆粒涂層的紡織材料的制備方法有多種。最方便和最流行的方法之一是使用各種還原劑對金屬離子進(jìn)行原位還原。在這種方法中,金屬離子首先沉積在紡織纖維上,然后通過化學(xué)還原轉(zhuǎn)化為納米顆粒。硼氫化鈉是最著名的還原劑之一,用于在紡織纖維上合成納米顆粒,如Ag。最近,對使用環(huán)境友好型工藝的要求越來越高,如生物合成(例如,使用植物提取物)、光或紫外線還原、電子還原或冷等離子體還原。冷等離子體被認(rèn)為是一種環(huán)境友好、快速和簡便的方法,用于合成表面高分散度的小金屬納米顆粒。通過使用等離子體處理來合成表面的金屬納米顆粒,避免了聚集,并提高了納米顆粒的催化活性和穩(wěn)定性。應(yīng)用冷等離子體時(shí),高能電子和氫物種(含氫氣體如氨、甲烷、氫氣、乙醇或水蒸氣被用作工作氣體)可以作為還原劑,將金屬離子轉(zhuǎn)化為原子和納米顆粒。在大氣壓等離子體中,電子的能量因電子與其他重金屬原子和分子之間的頻繁碰撞而降低;因此,僅靠高能電子無法有效地還原金屬離子,必須同時(shí)使用含氫氣體。Ar/He等離子體合成AgNP的機(jī)制顯示在以下反應(yīng)中:

Fan等使用DBD等離子體(5.7 kV, 10.4 kHz)在棉花上合成AgNP。這個(gè)過程包括用硝酸銀(AgNO3)和PVP浸漬棉樣,離心,以及DBD等離子體處理。使用Ar/H2混合物作為處理氣體?;钚詺湮锓N(包括H、H*和H2*)將Ag離子還原成納米顆粒。在合成AgNP后,棉花樣品的顏色從白色變?yōu)辄S色和棕色。使用SEM、X射線衍射、FTIR、XPS、SEM和透射電子顯微鏡(TEM)確認(rèn)了棉纖維上AgNP的制造。合成的納米粒子的平均尺寸約為5 nm。所制備的涂層在超聲處理30 min后顯示出良好的堅(jiān)牢度。用這種方法包覆的棉樣對革蘭氏陽性和革蘭氏陰性細(xì)菌顯示出很高的抗菌活性。
Li等使用氬氣輝光放電在棉織物上合成了AgNP。將棉花樣品在室溫下浸泡在含有硝酸銀和聚乙烯吡咯烷酮的溶液中1 h,然后將其置于功率為6~12 W的氬氣輝光放電等離子體中3 min。合成的納米粒子的尺寸從4.4 nm到6.3 nm不等(圖15)。涂有AgNP的棉樣對革蘭氏陽性和革蘭氏陰性細(xì)菌均有顯著抗菌活性。

圖15. (a)TEM;(b)粒度分布;(c)使用氬氣輝光放電在棉織物上合成的AgNP的SEM圖像。經(jīng)Elsevier Ltd.許可,轉(zhuǎn)載自參考文獻(xiàn),©2017。
Dong等使用DBD等離子體分兩步在無紡布PP上進(jìn)行表面活化和合成Ag納米顆粒。在第一步中,空氣DBD等離子體被用于PP的表面活化,以改善其潤濕性并提高TiO2NP在表面的負(fù)載。然后,將制備的樣品浸入AgNO3溶液中,并滴加氨水。AgNO3被轉(zhuǎn)化為AgOH,然后通過在60 ℃下干燥30 min轉(zhuǎn)化為Ag2O。通過隨后用H2/Ar(體積比為1∶1)DBD等離子體在22.5 W的功率下以30 mL·min-1的流速處理5 s,將Ag離子轉(zhuǎn)化為Ag納米顆粒。獲得的AgNP的直徑從4 nm到11 nm不等,平均直徑為7 nm。合成的AgNP增強(qiáng)了TiO2NP對亞甲基藍(lán)的光催化降解作用。在模擬陽光照射4 h的情況下,TiO2NP涂層PP無紡布上AgNP的存在,使染料去除率從73%提高到99%。
七、未來展望
目前世界范圍內(nèi)積極健康的生活方式的趨勢激發(fā)了人們對抗菌整理劑的興趣,特別是在紡織品上。目前,人們更加關(guān)注紡織品可能攜帶的微生物對人體健康的有害影響。因此,抗菌整理已經(jīng)成為當(dāng)前紡織品發(fā)展趨勢的一個(gè)關(guān)鍵過程。目前已經(jīng)有商業(yè)化的抗菌產(chǎn)品,特別是Ag、QAC、聚六亞甲基雙胍和三氯生,它們可以覆蓋大多數(shù)常見的紡織纖維(如棉、聚酯、尼龍、羊毛、再生纖維素、丙烯酸和PP)。人們對天然抗菌產(chǎn)品也很感興趣,如殼聚糖及其衍生物。此外,等離子體輔助整理技術(shù)具有快速、經(jīng)濟(jì)和環(huán)保等優(yōu)點(diǎn),是一種很有前景的紡織品整理技術(shù)。
等離子體在紡織品上的應(yīng)用帶來了一些嚴(yán)峻的挑戰(zhàn)。盡管從長遠(yuǎn)來看,等離子體可以提供經(jīng)濟(jì)的生產(chǎn),但最初的設(shè)置成本很高,需要對已經(jīng)存在的傳統(tǒng)設(shè)置進(jìn)行徹底的改變。這往往會使各行業(yè)不愿意采用這種技術(shù)。此外,與平面薄膜相比,紡織品的三維結(jié)構(gòu)和較高的表面積也有一些實(shí)際問題??偟膩碚f,考慮到第一次應(yīng)用是在20世紀(jì)80年代,等離子體在大規(guī)模紡織品生產(chǎn)中的應(yīng)用一直進(jìn)展緩慢。但由于商業(yè)上可用的機(jī)器和令人鼓舞的工業(yè)設(shè)置的例子,其進(jìn)展是相當(dāng)穩(wěn)定的。例如,Europlasma(比利時(shí))、Textilveredelung Grabher GmbH(奧地利)和HTP Unitex(意大利)使用低壓等離子體來處理紡織品表面,以增加潤濕性和附著力,從而改善紡織品的整理。Sefar AG(瑞士)使用大氣等離子體裝置,可以以25 m·min-1的速度運(yùn)行,同時(shí)處理寬達(dá)4 m的紡織品。目前市場上也有幾家等離子體機(jī)械設(shè)備供應(yīng)商,如IPLAS、Ahlbrandt、Softal Corona & Plasma GmbH和Diener electronic(德國),Coating Plasma Innovation(CPI)和AcXys(法國),Tri-Star(美國),GRINP、Arioli和Mascioni(意大利)以及Plasmatreat(新加坡),為等離子體在紡織領(lǐng)域的融入和進(jìn)步提供支持和機(jī)會。
紡織業(yè),特別是傳統(tǒng)的濕法工藝,在全世界的污染中占了很大的比例。對環(huán)境的日益關(guān)注也在推動各行業(yè)采用等離子體等環(huán)境安全技術(shù)。關(guān)于使用等離子體對紡織品進(jìn)行抗菌整理的研究也顯示出良好的效果和大規(guī)模應(yīng)用的合理性。盡管早期的紡織品抗菌整理大多集中在抗菌和抗真菌產(chǎn)品上,但紡織品抗病毒整理的開發(fā)也在興起。例如,Iyigundogdu等報(bào)道了五水合五硼酸鈉-三氯生處理的棉織物具有抗病毒、抗真菌、抗菌和抗感染的特性。Parthasarathi等報(bào)道了用經(jīng)等離子體增強(qiáng)碳氟化合物處理的非織造紡黏PP制成的手術(shù)服,根據(jù)美國醫(yī)療器械促進(jìn)協(xié)會(AAMI)分類,該手術(shù)服能夠提供抗病毒特性并具有4級液體屏障保護(hù)。
因此,考慮到等離子體的潛力和與傳統(tǒng)濕法整理有關(guān)的問題,在紡織品抗菌整理中采用等離子體技術(shù)可能是一種合理的方法,因?yàn)樵谀壳靶鹿谝咔槠陂g和之后對服裝的衛(wèi)生要求很高。
八、結(jié)論
微生物會對紡織品產(chǎn)生有害影響,并常常對紡織品的穿著者產(chǎn)生影響。目前全球的新冠疫情強(qiáng)調(diào)了保護(hù)人類免受微生物影響的責(zé)任。使用抗菌加工的紡織品可能是大眾免受微生物侵害和限制其傳播的最重要的盔甲。因此,紡織品的抗菌整理越來越重要,人們正在尋求更快的、經(jīng)濟(jì)的和環(huán)保的技術(shù)。為此,等離子體在紡織品中的應(yīng)用正變得至關(guān)重要。到目前為止,利用等離子體輔助進(jìn)行抗菌整理的研究已經(jīng)采用了各種方法。這包括整理劑在紡織品基材上的接枝聚合,改變紡織品的功能(如潤濕性)以增強(qiáng)整理劑的負(fù)載,等離子體濺射,以及在紡織品上合成納米顆粒以進(jìn)行抗菌保護(hù)。結(jié)果表明,所有的研究技術(shù)都取得了良好的效果,適合在抗菌整理中使用等離子體。因此,等離子體在紡織品抗菌整理中的應(yīng)用可以開創(chuàng)紡織品制造的新時(shí)代,實(shí)現(xiàn)可持續(xù)的環(huán)境和更健康的生活。

來源:中國工程院院刊